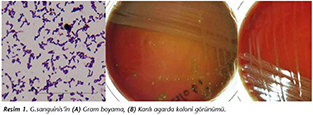

Femoral Hemodiyaliz Kateteri ile İlişkili Globicatella sanguinis Bakteremisi:
T�r D�zeyinde Tanımlamada Karşılaşılan Sorunlar*
Femoral Hemodialysis Catheter-Related Bacteremia Due to Globicatella sanguinis:
Challenges in Species Identification
Elif AKTAŞ1, Nafia Canan G�RSOY2, Tamer SAKACI3, Yener KO�3, Aziz Ahmad HAMİDİ4, Emin BULUT1,
Duygu ERDEMİR1, Barış OTLU2
1 Sağlık Bilimleri �niversitesi Şişli Hamidiye Etfal Eğitim ve Araştırma Hastanesi, Klinik Mikrobiyoloji Laboratuvarı, İstanbul.
1 Health Sciences University Şişli Hamidiye Etfal Training and Research Hospital, Clinical Microbiology Laboratory,
Istanbul, Turkey.
2 İn�n� �niversitesi Tıp Fak�ltesi, Tıbbi Mikrobiyoloji Anabilim Dalı, Malatya.
2 İn�n� University Faculty of Medicine, Department of Medical Microbiology, Malatya, Turkey.
3 Sağlık Bilimleri �niversitesi Şişli Hamidiye Etfal Eğitim ve Araştırma Hastanesi, Nefroloji Kliniği, İstanbul.
3 Health Sciences University Şişli Hamidiye Etfal Training and Research Hospital, Department of Nephrology, Istanbul, Turkey.
4 Sağlık Bilimleri �niversitesi Şişli Hamidiye Etfal Eğitim ve Araştırma Hastanesi, Enfeksiyon Hastalıkları ve
Klinik Mikrobiyoloji Kliniği, İstanbul.
4 Health Sciences University Şişli Hamidiye Etfal Training and Research Hospital, Department of Infectious Diseases and
Clinical Microbiology, Istanbul, Turkey.
* Bu �alışma, XXXVII. T�rk Mikrobiyoloji Kongresi (16-20 Kasım 2016, Antalya)'nde sunulmuştur.
�Z
Bu olguda diyabetik nefropati tanısıyla kronik hemodiyaliz programına alınan 43 yaşında kadın hastada saptanan Globicatella sanguinis'e bağlı kateterle ilişkili bakteremi olgusu sunulmuştur. Fırsat�ı ve nadir bir patojen olan Globicatella cinsinin laboratuvar tanısında kullanılan y�ntemler irdelenmiştir. Mayıs 2016 tarihinde hastanın bir set periferik kan k�lt�r� ve eş zamanlı olarak kateter k�lt�r� alınmıştır. �reyen bakterinin tanımlanması i�in biyokimyasal testler, Phoenix (BectonDickinson, ABD) ve MicroScan (BeckmanCoulter, ABD) otomatik identifikasyon sistemleri, matriks aracılı lazer desorpsiyon/iyonizasyon-u�uş zamanlı k�tle spektrometresi (MALDI-TOF MS) temelli Microflex MS (Bruker, Daltonics, Almanya) ve VITEK MS (database v2.0) (bioM�rieux, Fransa) sistemleri kullanılmıştır. Etkene �zg�l p8FPL 5'-AGT TTG ATC ATG GCT CAG-3' ve p806R 5'-GGA CTA CCA GGG TAT CTA AT-3' primerleriyle kısmi 16S rDNA dizi analizi yapılmıştır. Vankomisin, eritromisin, imipenem, sefotaksim ve benzipenisilin i�in minimum inhibit�r konsantrasyonu (MİK) agar gradient y�ntemiyle belirlenmiştir. Hastanın kan ve kateter k�lt�rlerinde aynı koloni �remesi tespit edilmiştir. Kanlı besiyerlerinde bir gecelik ink�basyon sonrası g�zlenen alfa-hemolitik, katalaz-negatif koloniler, Gram boyama ile gram-pozitif zincir yapan koklar şeklinde g�r�lm�şt�r. İzolat, Şişli Hamidiye Etfal Eğitim ve Araştırma Hastanesinde;� Bruker MS sistemi ile G.sulfidifaciens (skor değeri > 2), Phoenix otomatik identifikasyon sistemi ile G.sanguinis olarak tanımlanmıştır. İn�n� �niversitesi Tıp Fak�ltesinde; Microscan otomatize sistemiyle tanımlama yapılamamış, VITEK MS ile izolat %99.9 G.sanguinis ve %98.3 G.sulfidifaciens olarak isimlendirilmiştir. 16S rDNA dizi analiziyle izolat %100 Globicatella sanguinis (GenBank accessionno. KJ680157.1) olarak tanımlanmıştır. MİK değerleri vankomisin i�in 0.38 �g/ml, eritromisin i�in 1.5 �g/ml, imipenem i�in 0.38 �g/ml, sefotaksim i�in > 32 �g/ml ve benzipenisilin i�in 64 �g/ml olarak belirlenmiştir. Hastada katetere bağlı kan dolaşımı enfeksiyonu olarak d�ş�n�ld�ğ� i�in, tedaviye vankomisin 1 x 1 g IV/72 saat olarak 10 g�ne kadar devam edilmiştir. Hastanın kontrollerinde ateş ve �reme olmamıştır. G.sanguinis, sıklıkla karşılaşılan patojenler i�erisinde yer almadığından ve laboratuvar tanısında karşılaşılan g��l�kler nedeniyle belki de g�zden ka�abilmekte veya yanlış tanımlanabilmektedir. BD Phoenix veritabanında G.sulfidifaciens, Bruker MS veritabanında G.sanguinis ve MicroScan veritabanında Globicatella cinsinin mevcut olmadığı g�r�lm�şt�r. Son yıllarda gelişen tıbbi uygulamalar ve imm�n sistemi baskılanmış hasta pop�lasyonundaki artış nedeniyle nadir bakteri t�rleri daha da sık g�r�lecektir. Klinik mikrobiyoloji laboratuvarlarının, hem klasik mikrobiyolojik y�ntemlerle hem de molek�ler y�ntemlerle tanı g�c�n�n artırılması, ticari identifikasyon sistemi geliştiren şirketlerin patojen spektrumunu genişleterek veritabanlarını yenilemeleri bu t�r etkenlerle oluşabilecek ciddi enfeksiyonların �nlenmesi a�ısından �nem taşımaktadır.
Anahtar s�zc�kler: Globicatella; otomatize sistem; MALDI-TOF MS; 16S rDNA dizi analizi.
ABSTRACT
In this case, catheter-related bacteremia due to Globicatella sanguinis in a 43 years old female patient undergoing hemodialysis with the diagnosis of diabetic nephropathy was presented and the methods in the laboratory diagnosis of the rare opportunistic pathogen, Globicatella cins, were nvestigated. A set of peripheral blood cultures and simultaneous catheter culture was obtained from the patient in third of May 2016. Biochemical tests, Phoenix (Becton Dickinson, USA) and MicroScan (Beckman Coulter, USA) automated systems and matrix assisted laser desorption/ionization-time of flight-mass spectrometry (MALDI-TOF MS) based Microflex MS (Bruker, Daltonics, Germany) and VITEK MS (database v2.0) (bioM�rieux, France) systems were used for the identification of the cultured bacteria. Partial 16S rDNA sequencing was done by using specific p8FPL 5'-AGT TTG ATC ATG GCT CAG-3' and p806R 5'-GGA CTA CCA GGG TAT CTA AT-3' primers. Minimal inhibitory concentrations (MICs) for vancomycin, erythromycin, imipenem, cefotaxime and benzypenicillin were determined by agar gradient method. The blood and catheter cultures yielded the same type of bacterial colonies. Alfa-hemolytic, catalase negative colonies observed on blood agar plates after an over night incubation yielded gram-positive cocci on Gram staining. In Şişli Hamidiye Etfal Hospital, the isolate was identifed as G.sulfidifaciens (score value > 2) by Bruker MS system and as G.sanguinis by Phoenix automated system. In In�n� University, the isolate could not be identified by Microscan automated system while VITEK MS named the isolate as 99.9% G.sanguinis and 98.3% G.sulfidifaciens. The 16S rDNA sequencing identifed the isolate as 100% G.sanguinis (GenBank accessionno. KJ680157.1). The MIC values were 0.38 �g/ml, 1.5 �g/ml, 0.38 �g/ml, > 32 �g/ml and 64 �g/ml for vancomycin, eryrthromycin, imipenem, cefotaxime and benzylpenicillin, respectively. The patient was diagnosed as catheter-related bacteremia and vancomycin (1 x 1 g IV/72 h) was used for up to 10 days. No fever and bacterial growth in cultures were present in her control visits. As G.sanguinis is not among the commonly encountered pathogens and due to difficulties in laboratory diagnosis, it may be missedor mis-identified in clinical laboratories. BD Phoenix and Bruker MS data bases lack G.sulfidifaciens and G.sanguinis, respectively, while the Globicatella genus is not present in MicroScan database. The increased number of medical implementations and the increasing number of immunosuppressed patient populations in recenty ears will lead to the emergence of rare bacteria. Increasing the diagnostic power of clinical microbiology laboratories by conventional and molecular methods and renewal of the databases of commercial identification systems by expanding the pathogen spectrum are significantly important for the prevention and control of infections caused by these agents.
Keywords: Globicatella; automated systems; MALDI-TOF MS; 16S rDNA sequencing.
Geliş Tarihi (Received): 18.10.2016 • Kabul Ediliş Tarihi (Accepted): 08.03.2017
GİRİŞ
Globicatella cinsi, daha �ok insanlardan izole edilen Globicatella sanguinis ve sıklıkla hayvanlardan izole edilen Globicatella sulfidifaciens olmak �zere iki t�re sahip, nadir g�r�len, fırsat�ı patojen bir bakteridir1,2. Ancak her iki t�r�n de herhangi bir belirti vermeden insanlarda bulunabildiği g�sterilmiştir3. Globicatella t�rlerinin diğer katalaz-negatif, gram-pozitif koklardan ayırımı g��t�r. Bu ama�la Gram boyama ile g�r�n�mleri ve �eşitli biyokimyasal reaksiyonları kullanılmakta, ancak net bir t�r ayırımı yapabilmek i�in bunların yanı sıra 16S rDNA dizileme gibi genotipik y�ntemler ve/veya protein paterninin karşılaştırılması gerekmektedir1-9.
Bu olguda; diyabetik nefropati tanısıyla kronik hemodiyaliz programına alınan 43 yaşında kadın hastada saptanan G.sanguinis'e bağlı kateterle ilişkili bakteremi olgusu sunulmuştur ve Globicatella cinsinin laboratuvar tanısında kullanılan y�ntemler irdelenmiştir.��
OLGU SUNUMU
Şişli Hamidiye Etfal Eğitim ve Araştırma Hastanesi Nefroloji Polikliniğinde diabetes mellitus, hipertansiyon ve diyabetik nefropatiye bağlı kronik b�brek yetmezliği tanısıyla takip edilen 43 yaşındaki kadın hastaya Aralık 2015 tarihinde koroner damar hastalığı nedeniyle anjiyografi ve stent koyma işlemi yapılmış ve o tarihten itibaren haftada 3 g�n 4 saat d�zenli hemodiyaliz tedavisi başlanmıştır. Ge�ici sağ femoral kateterinden hemodiyaliz tedavisi almakta olan hasta �ş�me, titreme ve ateş şik�yetleriyle hastanemiz hemodiyaliz merkezine başvurduğunda; hemodiyaliz kateterinin etkin �alışmadığı g�zlendi. Hastanın fizik muayenesinde genel durumu iyi, bilinci a�ık, oryante, koopereydi. TA: 150/80 mmHg, ateş: 36.8�C, solunum sayısı: 18/dakika olarak saptandı. Sistem muayenelerinde patolojik �zellik saptanmadı. Yapılan rutin laboratuvar tetkiklerinde; l�kosit: 8470/�l, hemoglobin: 9.1 g/dl, hematokrit: %27.4, trombosit: 553.000/�l, glukoz: 204 mg/dl, kreatinin: 6.2 mg/dl, �re: 95 mg/dl, total protein: 6.8 g/dl, albumin: 3.9 g/dl, CRP: 6 mg/L olarak saptandı.
Mayıs 2016 tarihinde hastanın birer set periferik kan k�lt�r� ve kateter k�lt�r� alındı. Femoral kateteri �ekilip, ge�ici sağ juguler kateter takıldı, hemodiyalize alındı ve diyaliz sonrası 1 g parenteral vankomisin uygulandı. BACTEC 9240 (Becton Dickinson Diagnostic Instrument Systems, Sparks, ABD) otomatize kan k�lt�r sisteminde pozitif sinyal veren �rnekler; %5 koyun kanlı agar ve �ikolata agara ekilerek, %5 CO2'li ortamda 37oC'de ink�be edildi. Hastanın kan ve kateter k�lt�rlerinde bir gecelik ink�basyon sonrası �reyen koloniler alfa-hemolitik, katalaz-negatif, Gram boyama ile gram-pozitif zincir yapan koklar şeklinde g�r�ld� (Resim 1).
İzolat, Şişli Hamidiye Etfal Eğitim ve Araştırma Hastanesinde; Phoenix otomatik identifikasyon sistemi (Becton Dickinson, ABD) ile G.sanguinis olarak tanımlandı. Matriks aracılı lazer desorpsiyon/iyonizasyon-u�uş zamanlı k�tle spektrometresi (MALDI-TOF MS) temelli Microflex MS (Bruker, Daltonics, Almanya) platformunda MALDI Biotyper 3.1 yazılımı kullanılarak G.sulfidifaciens olarak tanımlandı (skor > 2). BD Phoenix veritabanında G.sulfidifaciens ve Bruker MALDI Biotyper k�t�phanesinde ise G.sanguinis'in mevcut olmadığı g�r�ld�. İzolatın biyokimyasal profili değerlendirildiğinde; H2S ve -glucuronidase �retiminin olmaması, pyridonylaryl amidase ve -N-acetyl glucosaminidase �retimi vehipurat hidroliz testinin pozitif olması4,5 G.sanguinis olma olasılığını g��lendirdi.
Daha sonra İn�n� �niversitesi Tıp Fak�ltesine g�nderilen izolatın Microscan (Beckman, Coulter, ABD) otomatize sistem ile tanımlaması yapılamadı ve sistemin veritabanı incelendiğinde Globicatella cinsinin bulunmadığı g�r�ld�. Aynı merkezde izolat, MALDI-TOF MS-temelli VITEK MS (database v2.0) (bioM�rieux, Fransa) sistemi ile %99.9 G.sanguinis ve %98.3 G.sulfidifaciens olarak tanımlandı. İzolatın t�r d�zeyinde kesin identifikasyonu i�in �zg�l p8FPL 5'-AGT TTG ATC ATG GCT CAG-3' ve p806R 5'-GGA CTA CCA GGG TAT CTA AT-3' primerleri kullanılarak kısmi 16S rDNA dizi analizi yapıldı. Bu ama�la EZ1 otomatize ekstraksiyon sistemi (Qiagen, Hilden, Almanya) kullanılarak DNA izolasyonu yapıldı ve ardından yaklaşık 800 baz �iftlik 16S rDNA b�lgesi her iki y�nde; GeneAmp PCR System 9700 (Applied Biosystems/ABD) ısı d�ng� cihazı kullanılarak �oğaltıldı. Amplifikasyon koşulları; 94�C'de 3 dakikalık ilk denat�rasyonu takiben, 35 d�ng� olarak 94�C/30 sn denat�rasyon, 60�C/30 sn bağlanma ve 72�C/1 dk uzama olarak uygulandı. %1'lik agaroz jel elektroforezinde elde edilen bantlar dizi analizinde kullanılmak �zere; "QIAquick Gel Extraction" kiti (Hilden, Almanya) kullanılarak saflaştırıldı. "ABI PrismBigDyeTerminator v3.1 (AppliedBiosystems, ABD)" kiti kullanılarak, "dideoxy nucleotide sequencing" işlemi ger�ekleştirildi. Sekans �r�nleri, ABI Prism 310 Genetic Analyser (Applied Biosystems, ABD) cihazına y�klendi ve elde edilen kromatogramlar, NCBI'da (National Centre for Biotechnology Information) yer alan Gen Bankası ve BLAST (Basic Local Alignment Tool) sunucusu kullanılarak veri bankasında kayıtlı diğer izolatlar ile karşılaştırıldı. Elde edilen dizilerin t�r d�zeyinde identifikasyonlarında y�ksek oranda doğruluğundan emin olmak i�in; E-değeri 0.0 ve maksimum benzerlik oranları %99'un �zerinde olan veriler tanımlamada kullanıldı. Toplamda yaklaşık 800 bp'lik b�lgenin dizi analizi yapıldı ve izolat; %100 G.sanguinis (GenBank accessionno. KJ680157.1) ve %99 G.sulfidifaciens (GenBank accessionno. KT825515.1) olarak tanımlandı.
�eşitli antibiyotikler i�in minimum inhibit�r konsantrasyonu (MİK) agar gradient y�ntemiyle belirlendi. MİK değerleri; vankomisin i�in 0.38 �g/ml, eritromisin i�in 1.5 �g/ml, imipenem i�in 0.38 �g/ml, sefoktaksim i�in > 32 �g/ml ve benzipenisilin i�in 64 �g/ml olarak belirlendi. Hastada katetere bağlı kan dolaşımı enfeksiyonu d�ş�n�ld�ğ� i�in tedavisine vankomisin 1 x 1 g IV/72 saat olarak 10 g�ne kadar devam edildi. Kontrollerinde ateşi tekrarlamayan hastanın k�lt�rlerinde �remesi ve ek bir şik�yeti olmadı.
TARTIŞMA
�eşitli mukozal y�zeylerde kalıcı flora elemanı olarak bulunabilen, insan ve hayvanlarda fırsat�ı patojen olduğu belirtilen G.sanguinis; 16S rDNA dizi analizleri yapılana kadar Streptococcus uberis olarak tanımlanmakta olup, 1992 yılında yeni bir takson olarak kabul edilmiştir1,6. G.sanguinis'in; bakteremi ve endokarditli hastaların kan k�lt�rlerinden, �riner sistem enfeksiyonlu hastaların idrarından, menenjitli hastaların beyin omurilik sıvılarından, cerrahi alan enfeksiyonlarından izole edildiği ve kuzularda meningoensefalit salgınına neden olduğu bildirilmiştir3-8. Globicatella cinsine ait ikinci bir t�r G.sulfidifaciens ise daha �ok hayvanlardan izole edilmekte ve 16S rDNA dizisi G.sanguinis ile %99.2 oranında benzerlik g�sterebilmektedir. Ancak t�m h�cre protein paterni ve biyokimyasal profili incelendiğinde t�r ayrımı daha net yapılabilmektedir2. �alışmada; eş zamanlı olarak Phoenix otomatik identifikasyon sistemi ve Bruker Microflex MS ile �alışılan izolat, t�r d�zeyinde farklı sonu�lar vermiştir. Bu iki sistemin veritabanları incelendiğinde; her birinin Globicatella cinsine ait yalnızca birer t�r i�erdiği, MicroScan veritabanında ise Globicatella cinsinin bulunmadığı g�r�lm�şt�r. VITEK MS, veritabanında bulunan her iki t�r i�in de birbirine �ok yakın y�zdelerle tanımlama yapmıştır (%99.9 G.sanguinis ve %98.3 G.sulfidifaciens). İzolatın t�r d�zeyinde kesin identifikasyonu i�in yapılan 16S rDNA dizi analizi sonucunda izolat, %100 G.sanguinis olarak tanımlanmıştır.
Klinik laboratuvarlarda Globicatella ile nadiren karşılaşıldığından, biyokimyasal ve metabolik �zelliklerinin kullanıldığı fenotipik test sonu�ları alışılmışın dışında kalmaktadır. Bu y�zden tanımlanamayan streptokok benzeri organizma veya biyokimyasal profilinin benzerliğinden dolayı Aerococcus viridans olarak bildirilmekte ya da g�zden ka�abilmektedir1,5. Son yıllarda gelişen tıbbi uygulamalar ve imm�n sistemi baskılanmış hasta pop�lasyonundaki artış ile birlikte, antibiyotiklerin se�ici baskısı şimdiye kadar tanımlanmamış mikroorganizmaların g�r�lme sıklığını artırmaktadır. Yeni ve nadir g�r�len mikroorganizmaların giderek artan oranlarda tespitinin bir başka nedeni de; 16S rDNA dizi analizi gibi molek�ler ve k�tle spektrometresi gibi yeni proteom bazlı y�ntemlerin rutin mikrobiyoloji laboratuvarlarında yerini almasıdır. �zellikle imm�ns�presyon, invaziv girişim, diyabet ya da kronik hastalıkları olan hasta grubu i�in ciddi risk oluşturan, �oğunlukla fırsat�ı olan ve mortal seyredebilen bu yepyeni mikroorganizmaların enfeksiyon etkeni olduğuna karar vermek, patojenite mekanizmalarını belirlemek, uygun antibiyotik tedavisini planlamak, ger�ek-zamanlı s�rveyanslarını oluşturmak ve enfeksiyon y�netim stratejilerini belirlemek i�in doğru bir şekilde t�r d�zeyinde tanımlanabilmesi şarttır9. G.sanguinis, sıklıkla karşılaşılan patojenler i�erisinde yer almadığından ve laboratuvar tanısında karşılaşılan g��l�kler nedeniyle belki de g�zden ka�abilmekte veya yanlış tanımlanabilmektedir. BD Phoenix veritabanında G.sulfidifaciens, Bruker MS veritabanında G.sanguinis ve MicroScan veritabanında Globicatella cinsinin mevcut olmadığı g�r�lm�şt�r.
Son yıllarda gelişen tıbbi uygulamalar ve imm�n sistemi baskılanmış hasta pop�lasyonundaki artış nedeniyle nadir bakteri t�rleri daha sık g�r�lecektir. G�n�m�zde hen�z tek başına t�m bakteriyel t�rleri tanımlayabilecek m�kemmel bir y�ntem bulunmamaktadır. Klinik mikrobiyoloji laboratuvarlarının, hem klasik mikrobiyolojik y�ntemlerle hem de molek�ler y�ntemlerle tanı g�c�n�n artırılması, ticari identifikasyon sistemi geliştiren şirketlerin patojen spektrumunu genişleterek veritabanlarını yenilemeleri bu t�r etkenlerle oluşabilecek ciddi enfeksiyonların �nlenmesi a�ısından �nem taşımaktadır.
KAYNAKLAR
- Collins MD, Aguirre M, Facklam RR, Shallcross J, Williams AM. Globicatella sanguis gen. nov., sp. nov., a new gram-positive catalase-negative bacterium from human sources. J Appl Bacteriol 1992; 73(5): 433-7.
- Vandamme P, Hommez J, Snauwaert C, et al. Globicatella sul�diffaciens sp. nov. Isolated from purulent infections in domestic animals. Int J Syst Evol Microbiol 2001; 51(5): 1745-9.
- H�ry-Arnaud G, Doloy A, Ansart S, et al. Globicatella sanguinis meningitis associated with human carriage. J Clin Microbiol 2010; 48(4): 1491-3.
- Lau SKP, Woo PCY, Li NKH, et al. Globicatella bacteraemia identified by 16S ribosomal RNA gene sequencing. J Clin Pathol 2006; 59(3): 303-7.
- Abdul-Redha RJ, Balslew U, Christensen JJ, Kemp M. Globicatella sanguinis bacteraemia identified by partial 16S rRNA gene sequencing. Scand J Infect Dis 2007; 39(8): 745-8.
- Matusnami M, Otsuka T, Ohkusu K, Sogi M, Kitazono H, Hosokawa N. Urosepsis caused by Globicatella sanguinis and Corynebacterium riegelii in an adult: case report and literature review. J Infect Chemother 2012; 18(4): 552-4.
- Jain N, Mathur P, Misra MC. Globicatella sanguinis meningitis in a post head trauma patient: first case report from Asia. J Infect Dev Ctries 2012; 6(7): 592-4.
- Vela AI, Fern�ndez E, lasHeras A, et al. Meningoencephalitis associated with Globicatella sanguinis infection in Lambs. J Clin Microbiol 2000; 38(11): 4254-5.
- Loong SK, Khor CS, Jafar FL, AbuBaka S. Utility of 16S rDNA sequencing for identification of rare pathogenic bacteria. J Clin Lab Anal 2016; 30(6): 1056-60.
İletişim (Correspondence):
Do�. Dr. Elif Aktaş,
Sağlık Bilimleri �niversitesi Şişli Hamidiye Etfal Eğitim ve
Araştırma Hastanesi, Tıbbi Mikrobiyoloji Laboratuvarı,
İstanbul, T�rkiye
Tel (Phone): +90 212 373 5000,
E-posta (E-mail): drelifaktas@yahoo.com